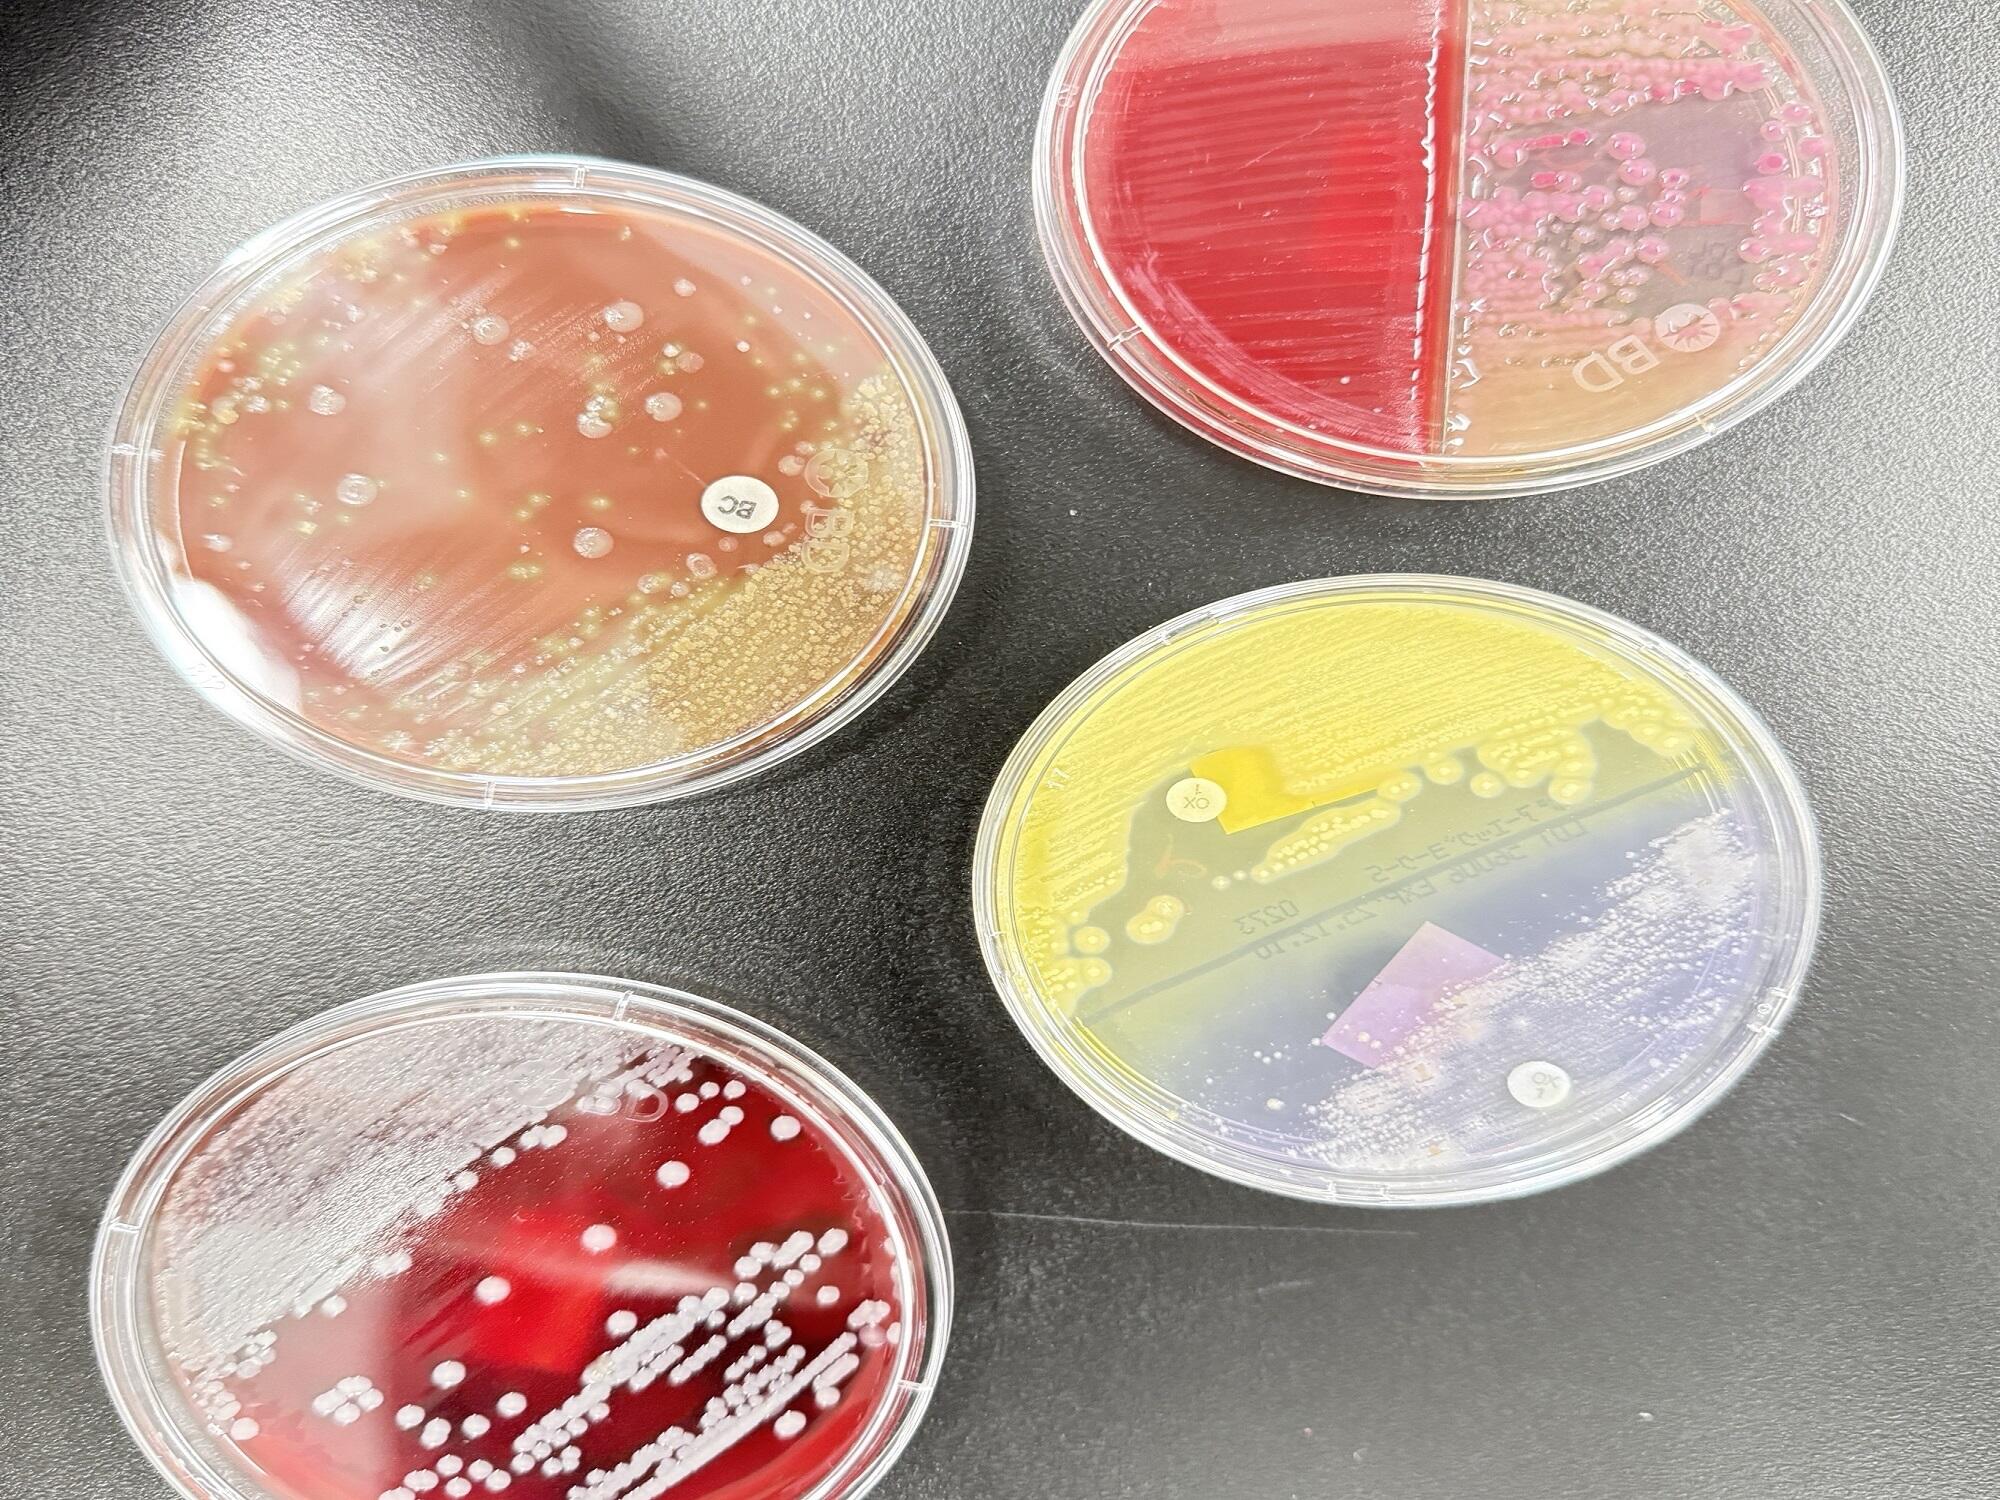

臨床検査科について
臨床検査科は現在、常勤職員13名、非常勤職員2名が所属しています。
採血室、検体検査室、生理機能検査室、細菌検査室に分かれて迅速かつ正確な検査結果を提供し病気の早期発見・治療に役立てるよう日夜活動しています。
当検査科は、救急患者さんの受入れや入院患者さんの急変に備え、24時間オンコール体制で救急対応を行っています。
採血室
採血室では、看護師と臨床検査技師が医師から依頼された検査のための血液や尿などの採取を行っています。患者さんに安心して検査を受けていただけるよう、丁寧な声掛けと安全で正確な手技を心掛けています。
※内容によって順番が前後する場合があります。必ずしも順番どおりになりませんことをご理解いただきますようお願いいたします。
【採血場所のご案内】
採血・採尿の受付は、8:30から始めます。
8:30~13:00 1階 採血室
13:30~17:15 2階 生理機能検査室

検体検査室
検体検査室では主に以下の検査を実施しています。
一般検査
尿検査及び便潜血検査などの一般検査を通じて、さまざまな疾患の早期発見や診断、治療方針の決定に尽力しています。
【尿検査】
尿検査は、腎臓や尿路系の疾患だけでなく、糖尿病などの全身疾患の兆候をとらえる基本かつ重要な検査です。尿中の蛋白・糖・潜血・pH・比重などの検査項目を測定し、必要に応じて顕微鏡を用いた尿沈渣検査を実施します。これにより、赤血球、白血球、上皮細胞、円柱、結晶などの有無を観察し、より詳細な情報を臨床医に提供します。
【便潜血検査】
便潜血検査は、目に見えない微量な血液(潜血)を検出する検査で、主に大腸がんやポリープなどのスクリーニングに用いられます。便の中に血液が混ざっているかどうかを調べることで、消化管からの出血の有無を早期に確認することができます。

血液・凝固検査
当院では、臨床検査技師が血清(末梢血液一般検査)及び凝固検査を通じて、患者さんの健康状態の評価と疾患の早期発見に努めています。また、鼻汁中好酸球数検査(鼻汁の中の好酸球数を調べる検査)を実施しており、アレルギー性鼻炎や花粉症などの診断に貢献しています。
【血液検査】
血液検査では、多項目自動血球分析装置を用いて以下のような項目を調べています。
白血球の数や種類:身体の中で炎症が起きているか、感染症や白血病などの病気が疑われる場合に確認します。
赤血球やヘモグロビンの量:貧血の有無や、その種類を調べることができます。
血小板の数:出血しやすくなっていないかなどを確認します。
また、白血病などでみられる異常な細胞や、形に変化がある血球(赤血球・白血球・血小板)は、臨床検査技師が顕微鏡で詳しく観察してチェックしています。

【凝固検査】
凝固検査では、血液が適切に固まるかどうかを調べる検査です。
手術や出血をともなう治療の前に、安全に処置が行えるかどうかを確認するために重要です。血液をサラサラにする薬(例:ワーファリン)の効果判定に活用されます。
DダイマーやFDPは血管の中で血のかたまり(血栓)ができていないか調べることができ、深部静脈血栓症などの血栓症の可能性を評価します。
【鼻汁中好酸球数検査】
鼻汁中好酸球数検査は、顕微鏡を使って鼻水中の好酸球数を調べる検査であり、アレルギー性鼻炎や花粉症などの診断に用いられます。好酸球が陽性となる場合、アレルギー反応が起きている可能性が高く、特に鼻汁中の好酸球数が増加していると、アレルギー性疾患が強く疑われます。非アレルギー性の鼻汁では、好酸球の増加はほとんど見られないため、風邪とアレルギー性鼻炎の鑑別に有用な指標となります。
生化学的検査・免疫学的検査
採取された血液や尿などを用いて生化学的検査(肝機能・腎機能、脂質、糖代謝、電解質など)や免疫学的検査(B型・C型肝炎ウイルスや梅毒などの感染症や前立腺がんなどの腫瘍マーカー等)を行い身体の状態を調べ、患者さんの健康管理や病気の診断に貢献しています。
以下の表に主な検査の目的と検査項目をまとめてお示しします。
| 検査の目的 | 主な検査項目 |
| 肝臓 | AST、ALT、γ-GT |
| 腎臓 | BUN(尿素窒素)、CRE(クレアチニン) |
| 心臓 | CK、CK-MB、BNP、NT-proBNP、トロポニンI |
| 膵臓 | アミラーゼ |
| 糖尿病 | グルコース、HbA1c |
| 動脈硬化 | 総コレステロール、中性脂肪、HDLコレステロール、LDLコレステロール |
| 貧血 | 鉄(Fe)、フェリチン |
| 炎症反応 | CRP |
| 感染症 | B型肝炎・C型肝炎ウイルス、梅毒 |
| 腫瘍マーカー | CEA、AFP、CA19-9、CA125、total PSA |


輸血関連検査
当院では、認定輸血検査技師が中心となり、院内で使用する輸血用血液(自己血、同種血)の管理や検査を行っています。患者さんに安心して治療を受けていただけるよう、安全かつ適切な輸血療法の実践を目指し、輸血業務に取り組んでいます。

細菌検査室
細菌検査室では、患者さんから採取された検体(喀痰・尿・血液など)を用いて病原菌の検出や薬剤感受性の確認を行い、感染症の診断と治療をサポートしています。また、感染対策チーム(ICT)の一員としての活動も行っています。ICTとは病院内において感染症の発生や拡大を防止するために設置される専門チームです。当院は、感染対策向上加算Ⅰを取得しており、大村市内の病院や離島(壱岐・対馬)の病院と連携し、相互ラウンドやカンファレンスを通じた情報共有を行い、地域全体の感染対策水準の向上に取り組んでいます。

病理検査室
病理組織検査と細胞診検査について
病理検査室では、患者さんの診断や治療方針の決定に欠かせない「病理組織検査」と「細胞診検査」を行っています。
【病理組織検査】:手術や内視鏡などで採取された組織を顕微鏡で詳しく観察し、病気の種類や進行度を明らかにします。
【細胞診検査】:痰・尿・体腔液などに含まれる細胞や子宮頸部などから採取された細胞を調べ、がんや炎症の有無を評価します。
採取された組織や細胞から臨床検査技師が標本を作製しています。病理組織検査は、病理専門医が診断を行い、細胞診検査は細胞検査士2名で全例ダブルチェックし病理専門医の診断補助を行っています。
実績(例年の平均)
組織診検査 1,100件
細胞診検査 3,000件

生理機能検査室
生理機能検査は、患者さんの身体に直接器具を取り付け、心臓や脳、呼吸、血流、睡眠などの生体機能をリアルタイムで測定・記録する検査です。主に「電気的な活動(電気信号)」や「超音波」「呼吸機能」などを観察することで、病気の診断・重症度の判定・治療効果の評価に活用されます。侵襲が少なく、患者さんの身体的負担が少ないことも特徴です。
当院では以下のような生理機能検査を実施しています。
【心電図検査】
心電図検査機器を用いて心臓のリズムや電気的活動を詳しく評価しています。検査は非侵襲的で痛みもなく、心房細動や心筋梗塞などの異常を発見することが可能です。

【ホルター心電図】
ホルター心電図は、24時間または数日間にわたり日常生活中の心電図を記録し、不整脈や動悸、失神などの症状を評価する検査です。当院では通常のホルター心電図に加え、症状が少ない方にも対応可能なイベントホルターも用意しています。カテーテルアブレーションなどの専門的治療の、術前評価にも使用しています。
【運動負荷試験】(トレッドミル試験)
トレッドミル試験を実施し、運動時の心臓の状態を詳しく評価しています。この検査では、専用のベルトコンベア(トレッドミル)上で歩行や軽いジョギングを行いながら心電図と血圧を同時に測定します。運動中に現れる狭心症や不整脈の有無、心機能の状態を詳細に把握でき、無症状の心疾患の早期発見や治療効果の評価にも有用です。検査は専門スタッフが安全に配慮して行い、患者さんの体調に合わせた無理のない負荷設定を行います。
【心肺運動負荷試験】(CPX)
エルゴメータで運動を行いながら、心臓・肺・筋肉の動きを総合的に評価する検査です。呼吸や脈拍、血圧、酸素摂取量などを測定し、心不全や呼吸器疾患の診断、運動耐容能の評価、リハビリや治療効果の判定に活用されます。症状が運動時に現れる方や、運動制限の程度を知りたい方に有用です。

【呼吸機能検査】
呼吸機能検査により肺の健康状態を詳しく評価しています。一般肺機能検査では、肺活量や呼気量を測定し、呼吸障害の有無や重症度を把握します。また、残気量検査により、肺に残る空気の量を測定し、閉塞性肺疾患の診断に役立てています。さらに、DLCO(肺拡散能)検査では、肺のガス交換能力を評価し、肺線維症や肺血管疾患の早期発見に貢献します。

【超音波検査】(エコー検査)
超音波検査は、放射線を使わずに体内の臓器や血管の状態をリアルタイムで観察できる安全かつ痛みのない検査方法です。
当院では、高精度の超音波検査機器を用いて、患者さんの健康管理と早期診断に努めています。
【心エコー】
心臓の動きや弁の機能、血流の状態を詳細に評価し、心疾患の早期発見に役立てています。
【腹部エコー】
肝臓、胆のう、膵臓、腎臓など腹部の主要臓器をチェックし、腫瘍や結石、炎症などの異常の有無を検索します。
【体表エコー】
甲状腺や乳腺、リンパ節など皮膚のすぐ下にある組織の異常を調べるのに適しています。
【頸動脈エコー】
脳卒中のリスク評価に重要な頸動脈の動脈硬化や狭窄の状態を詳しく検査します。
【下肢静脈エコー】
静脈瘤や深部静脈血栓症(DVT)など、下肢の静脈の異常の有無を検索します。
当院の専門技師が丁寧に検査を行い、迅速に結果を報告します。

【脳波検査】
脳の電気的な活動を測定する検査で、てんかん、意識障害、睡眠障害などの診断に使用されます。頭部に電極を装着し、安静状態や睡眠中の脳波を記録します。
【PSG】(終夜睡眠ポリグラフ検査)
睡眠時無呼吸症候群(SAS)などの睡眠障害の確定診断を目的とした精密検査です。一晩かけて脳波、呼吸、心拍、筋電図、いびき、酸素飽和度などを総合的に測定します。この検査によりSASの重症度や睡眠の質などの評価をすることができます。

認定資格(重複資格取得者あり)
医療技術部門管理資格(1名)
認定輸血検査技師(1名)
超音波検査士 循環器(4名)
超音波検査士 体表臓器(2名)
超音波検査士 消化器(3名)
超音波検査士 血管(1名)
JHRS認定心電図専門士(1名)
心臓リハビリテーション指導士(1名)
心不全療養指導士(1名)
日本睡眠学会認定検査技師(1名)
細胞検査士(2名)
国際細胞検査士(1名)
二級病理検査士(1名)
特定化学物質及び四アルキル鉛作業主任者(2名)
有機溶剤作業主任者(2名)
毒物劇物取扱責任者(4名)
精度管理責任者(2名)
臨地実習指導者(1名)

